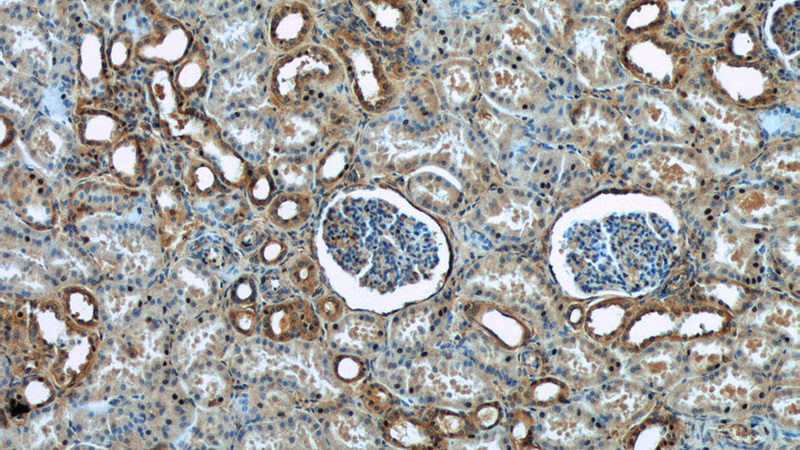
Immunohistochemistry of paraffin-embedded human kidney tissue slide using Catalog No:115963(HRD1 Antibody) at dilution of 1:50 (under 10x lens)

-
Product Name
SYVN1 antibody
- Documents
-
Description
SYVN1 Rabbit Polyclonal antibody. Positive IF detected in HepG2 cells. Positive IHC detected in human kidney tissue. Positive IP detected in mouse kidney tissue. Positive WB detected in HEK-293 cells, HepG2 cells, MDA-MB-453s cells, mouse kidney tissue, mouse ovary tissue, mouse pancreas tissue, mouse stomach tissue, NIH/3T3 cells, Raji cells, rat stomach tissue. Observed molecular weight by Western-blot: 68-76 kDa
-
Tested applications
ELISA, WB, IHC, IP, IF
-
Species reactivity
Human,Mouse,Rat; other species not tested.
-
Alternative names
HRD1 antibody; KIAA1810 antibody; Synovial apoptosis inhibitor 1 antibody; SYVN1 antibody
- Immunogen
-
Isotype
Rabbit IgG
-
Preparation
This antibody was obtained by immunization of SYVN1 recombinant protein (Accession Number: NM_172230). Purification method: Antigen affinity purified.
-
Clonality
Polyclonal
-
Formulation
PBS with 0.02% sodium azide and 50% glycerol pH 7.3.
-
Storage instructions
Store at -20℃. DO NOT ALIQUOT
-
Applications
Recommended Dilution:
WB: 1:500-1:5000
IP: 1:500-1:5000
IHC: 1:20-1:200
IF: 1:50-1:500
-
Validations

HEK-293 cells were subjected to SDS PAGE followed by western blot with Catalog No:115963(HRD1 antibody) at dilution of 1:1000

IP Result of anti-HRD1 (IP:Catalog No:115963, 4ug; Detection:Catalog No:115963 1:1000) with mouse kidney tissue lysate 7200ug.
Immunohistochemistry of paraffin-embedded human kidney tissue slide using Catalog No:115963(HRD1 Antibody) at dilution of 1:50 (under 10x lens)

Immunohistochemistry of paraffin-embedded human kidney tissue slide using Catalog No:115963(HRD1 Antibody) at dilution of 1:50 (under 40x lens)

Immunofluorescent analysis of (10% Formaldehyde) fixed HepG2 cells using Catalog No:115963(HRD1 Antibody) at dilution of 1:50 and Alexa Fluor 488-congugated AffiniPure Goat Anti-Rabbit IgG(H+L)
-
Background
HRD1is also named as SYVN1(Synovial apoptosis inhibitor 1) , KIAA1810. It acts as an E3 ubiquitin-protein ligase which accepts ubiquitin specifically from endoplasmic reticulum-associated UBC7 E2 ligase and transfers it to substrates, promoting their degradation. Two distinct binding sites mediate Hrd1 dimerization or oligomerization, one located within the transmembrane region and another within the cytosolic domain. (PMID:19864457).Western blot analysis detected abundant HRD1 expression in liver and kidney. Mouse liver and spleen expressed Hrd1 as an 85-kD protein(PMID:12646171).
-
References
- He K, Cunningham CN, Manickam N, Liu M, Arvan P, Tsai B. PDI reductase acts on Akita mutant proinsulin to initiate retrotranslocation along the Hrd1/Sel1L-p97 axis. Molecular biology of the cell. 26(19):3413-23. 2015.
- Williams JM, Inoue T, Banks L, Tsai B. The ERdj5-Sel1L complex facilitates cholera toxin retrotranslocation. Molecular biology of the cell. 24(6):785-95. 2013.
- Bernardi KM, Williams JM, Inoue T, Schultz A, Tsai B. A deubiquitinase negatively regulates retro-translocation of nonubiquitinated substrates. Molecular biology of the cell. 24(22):3545-56. 2013.
- Walczak CP, Ravindran MS, Inoue T, Tsai B. A cytosolic chaperone complexes with dynamic membrane J-proteins and mobilizes a nonenveloped virus out of the endoplasmic reticulum. PLoS pathogens. 10(3):e1004007. 2014.
Related Products / Services
Please note: All products are "FOR RESEARCH USE ONLY AND ARE NOT INTENDED FOR DIAGNOSTIC OR THERAPEUTIC USE"
